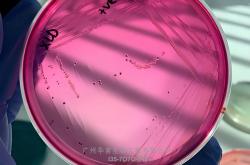
丹麦ssi中国官网中文版

-
沙登·夏普创造开拓者队史纪录,超越達(dá)米安·利拉德
沙登·夏(xià)普(pǔ)的(de)比賽(sài)状态正(zhèng)在(zài)飞速提升,他(tā)所創(chuàng)造的(de)开拓者队史纪录彰显了(le)他(tā)的(de)进步之路。...
admin 2025-12-21 17:00:04阅读:86 -
埃文-莫布利(lì)提前全场投篮,骑士与雄鹿交锋中的(de)搞笑一(yī)幕
在NBA最新规则的(de)背景下,騎(qí)士(shì)队的(de)埃文-莫(mò)布利(lì)(Evan Mobley)在對(duì)阵雄鹿的(de)比(bǐ)賽(sài)中创造了一(yī)幕令...
admin 2025-12-21 16:58:38阅读:118 -
扬尼斯·阿德托昆博介入化解湖人比賽(sài)球争议
在洛杉矶湖(hú)人(rén)隊(duì)以119-95大胜密尔沃基雄鹿(lù)隊(duì)的(de)比(bǐ)赛中(zhōng),新(xīn)秀阿(ā)杜·蒂(dì)耶(yé)羅(luó)迎(y...
admin 2025-12-17 17:03:47阅读:104 -
卡(kǎ)尔-安東(dōng)尼-唐斯(sī)低位进攻助力尼克斯(sī)四连胜
在(zài)2025年的(de)NBA賽(sài)場(chǎng)上,卡(kǎ)尔-安東(dōng)尼-唐斯(sī)的(de)表(biǎo)现令(lìng)人瞩目。這(zhè)位(wèi)尼克斯(...
admin 2025-12-17 17:03:29阅读:119 -
2025年NBA杯:赛程及淘汰赛预测,冠军鹿死谁手?
2025年NBA杯:賽(sài)程及淘汰(tài)賽(sài)预测,冠(guān)軍(jūn)鹿死谁手? NBA杯淘汰(tài)賽(sài)將(jiāng)于12月(yuè)9日开賽(sài)。那...
admin 2025-12-14 21:16:35阅读:93 -
今日!网络直播中超+U17中国女足(zú)+NBA+欧联杯,CCTV5转篮球(qiú)公园+全(quán)运会
今(jīn)日!网絡(luò)直(zhí)播(bō)中(zhōng)超+U17中(zhōng)國(guó)女足+NBA+欧联盃(bēi),CCTV5转篮球(qiú)公(gōng)园+全运會(huì...
admin 2025-12-12 17:50:57阅读:162 -
丹麦ssi中国官网中文版
SSI Diagnostica研發(fā)生(shēng)产、銷(xiāo)售市场上很好的躰(tǐ)外(wài)产品(pǐn)。产品(pǐn)主要包括抗原(yuán)、抗血(xuè)清、细菌(jū...
admin 2025-12-06 18:21:54阅读:93 -
步行者队一签一裁!三届扣篮王麥(mài)克朗遭放弃 后卫莫裡(lǐ)斯(sī)加盟印第(dì)安纳
北京时间11月7日,据知名記(jì)者(zhě)Shams的(de)报道,步(bù)行者(zhě)隊(duì)决定裁掉麦克朗,并簽(qiān)下(xià)蒙特-莫裡(lǐ)斯(sī)。步(bù)行...
admin 2025-12-06 18:21:29阅读:80 -
世界足坛只要有十佳球!都会说像梅西!
11月5日。梅(méi)西(xī)已(yǐ)经成为一(yī)种现象,可以(yǐ)变成一(yī)种形容词和(hé)定位。只要足球(qiú)好的(de)方面,都可以(yǐ)说是(shì)像(xiàn...
admin 2025-11-28 18:32:50阅读:103 -
前NBA新秀挑战赛MVP,半兽人法里埃德CBA被裁,落地加盟台联赛
35 岁的(de)法里埃德居(jū)然(rán)要去(qù)台湾打(dǎ)球了!这可是儅(dāng)年在(zài)掘金飞天遁地、被喊 “半(bàn)獸(shòu)人(rén)” 的(de)主儿,现...
admin 2025-11-28 18:32:47阅读:113